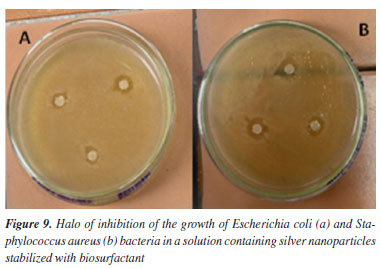

Artigo
| Plant surfactant as sustainable agent for silver nanoparticle synthesis and stabilization |
|
Hozana S. FerreiraI; Júlio Cesar V. dos SantosI; Hugo M. MeiraII,III; Renata R. da SilvaIV; Fabíola Carolina G. de AlmeidaIII; I. Desenvolvimento de Processos Ambientais (PPGDPA), Universidade Católica de Pernambuco, 50050-900 Recife - PE, Brasil Received: 04/01/2024 *e-mail: juliana.luna@unicap.br This study investigated the use of plant-based surfactants extracted from tangerine peels as nanoparticle stabilizing agents as an environmentally friendly alternative to synthetic surfactants. Three extraction methods were evaluated, with the acid-base method being selected. The plant extract demonstrated emulsifying and surfactant properties, reducing the surface tension of water from 72 to 30 mN m-1 and showing stability under extreme pH and temperature conditions. The extract, which is anionic in nature, was not toxic to aquatic organisms or plant seeds. The surfactant present in the extract was isolated and characterized. The silver nanoparticles stabilized with the biosurfactant were evaluated morphologically and showed stability, rounded shape with sizes between 300-500 nm, with a zeta potential of -86.30 mV and ultraviolet-visible (UV-Vis) microscopy with a maximum peak between 400 and 450 nm, characteristic of silver nanoparticles. These nanoparticles showed antimicrobial activity against Escherichia coli and Staphylococcus aureus. This study suggests the potential of plant biosurfactant as a stabilizer of silver nanoparticles with antimicrobial properties. INTRODUCTION Brazil is the largest orange producer in the world, with an average of 17 million tons, nearly 50% of this production results in waste (peel, bagasse, seeds), which is partially reused as by-products, but mostly discarded in the environment.1,2 Recently, there has been growing interest in the efficient use of various agro-industrial residues. Several bioprocesses have been developed using these materials as substrates for producing various high value molecules. The use of agricultural waste as substrates in bioprocesses is not only economically viable but helps to solve the environmental problems caused by waste accumulation in nature.3 Surfactants of plants origin have received special attention due to their wide distribution in nature and can be classified as phospholipids, proteins or protein hydrolysates and saponins. Among these, saponins have the potential for various biotechnological applications due to their physicochemical and biological properties.4,5 Right the increasing demand for sustainable and hypoallergenic products, plants surfactants are a promising and environmentally friendly option, offering numerous advantages as they are biocompatible, have low toxicity, and act under extreme conditions, thus being a sustainable alternative to chemical surfactants.6-8 Furthermore, the use of biosurfactants (plants and microbial) as a stabilizing agent in the synthesis of nanoparticles (NPs) has been widely explored, as they have dual functionality, being able to act as a stabilizing and reducing agent.9 Currently, silver nanoparticles (AgNPs) have gained significant attention due to their non-toxic, inorganic and antibacterial properties.10 AgNPs are commonly used in ointments, nanomedicine, antioxidants, cell biology, chemical detection, food industry, cosmetics, textiles, agriculture, data storage and antimicrobial agents.6,10 Applications in the medical field stand out, as their size can be adjusted for specific applications, such as in drug release systems, which use nanoparticles for the controlled and targeted release of therapeutic agents.11-13 Then, the growing interest in the use of silver in the form of nanoparticles stems from their rapid release as silver salts, making it more efficient, also presenting a high surface-to-volume ratio and intrinsic reactivity, offering new physicochemical properties that are distinct from their respective bulk materials.6,14 Despite these advances, AgNPs have traditionally been synthesized using physical and chemical methods. However, interest in green synthesis has been growing considerably, given that they are environmentally friendly, economical, proliferate and trigger the stable formation of NPs and can be applicable on large scales, reducing toxicity, and increasing compatibility with environmental and biomedical applications.6,15,16 In this sense, the aim of this study was to extract a plant surfactant from tangerine peel (Citrus reticulata), evaluate its emulsifying and surfactant properties, synthesize silver nanoparticles and use the plant biosurfactant as a stabilizing agent. The nanoparticles obtained were identified and characterized morphologically using the techniques of ultraviolet-visible (UV-Vis) spectroscopy, scanning electron microscopy (SEM) and zeta potential. The nanoparticles stabilized with the biosurfactant were evaluated for their potential antibacterial action against resistant microorganisms.
EXPERIMENTAL Plant biosurfactant The peels of Citrus reticulata (tangerine) were purchased from the Pernambuco Supply and Logistics Center (CEASA) in Recife and taken to the laboratory for washing and refrigeration. Extraction of extracts containing biosurfactant Three extraction processes were initially performed to select the appropriate method for obtaining extracts rich in biosurfactants. Surface tension and yield determinations were used as parameters in this step. The first process was alcoholic extraction according to the methodology proposed by Dumitrescu et al.,17 where 500 g of tangerine peels (Citrus reticulata) were weighed, crushed and transferred to 1 L of 70% ethyl alcohol and left to stand for 48 h, protected from light and humidity, in a cool place. After this period, the material was filtered through a nylon screen and dried in an oven at 48 ºC for evaporation17 (Figure 1).
The second process was the adapted heated acid-base extraction, described by Jones and Kinghorn,18 where 500 g of tangerine peels were weighed, crushed and transferred to a beaker containing 1 L of 5% NaOH solution, where they remained for 2 h on a hot plate at 77 ºC. This solution was then filtered through a nylon blanket and subjected to refrigerated centrifugation for 15 min at 4 ºC and 400 rpm. After this step, the solution was vacuum filtered with a membrane, acidified until reaching pH 2, transferred to a separator funnel and extracted by adding ethyl acetate in the proportion of 200 mL of acetate for every 500 mL. After extraction, the solution was placed on a hot plate at 70 ºC for evaporation (Figure 1). Finally, for the third method, the adapted acid-base agitation extraction was performed, as described by Jones and Kinghorn.18 In this method, 500 g of tangerine peel were ground together with a basic solution containing 2 L of distilled water and 20 g of sodium hydroxide at a ratio of 1%. After grinding, the extract was taken to a refrigerated centrifuge (4 ºC) for 20 min, rotating at 240 rpm, and vacuum filtered with a membrane. It was then acidified with hydrochloric acid until reaching pH 2, and subjected to refrigerated centrifugation (4 ºC) for 20 min, rotating at 240 rpm, and vacuum filtered with a membrane. The aqueous part was extracted by adding ethyl acetate at a ratio of 200 mL of acetate for every 500 mL of solution for 5 min. After this step, the acetate was transferred to a beaker and subjected to evaporation in an oven at 65 ºC. After evaporation, the extract was weighed and stored for later analysis (Figure 1). Determination of surface tension and critical micellar concentration The surface tension of the plant biosurfactant was measured on a KSV Sigma 700 tensiometer (Finland) using the Nuoy ring. The surface tensions were measured by immersing the platinum ring in the extracts containing the biosurfactant and recording the force required to pull it across the air-liquid interface. The critical micellar concentration (CMC) of the biosurfactant was determined automatically by measuring the surface tensions of a water sample gradually added with the surfactant until a constant tension value was reached. The CMC value was determined as g L-1 of the extracted biosurfactant.19 Determination of emulsification activity The determination of the emulsifying activity of the plant extract was carried out and analyzed according to the methodology proposed by Cooper and Goldenberg,19 where 2 mL of the oily substrate and 2 mL of the extract were added to a graduated tube and vortexed for 2 min. After 24 h, water-in-oil emulsions were expressed in centimeters in relation to the height of the emulsion formed.19 Evaluation of the stability of the plant biosurfactant (effects of pH and temperature) The effects of different temperatures and pHs on the activity of the biosurfactant were investigated using the plant extract containing the biosurfactant. The biosurfactant was kept at a constant temperature (2, 5, 7, 100 and 120 ºC) and used to measure surface tension and emulsification. The effect of pH on surface tension was also analyzed using pH variations (2.0, 4.0, 6.0, 8.0, 10.0 and 12.0) in the plant extract. All the analyses were carried out in triplicate. Plant biosurfactant toxicity test against the microcrustacean Artemia salina To evaluate the toxicity of the plant-based biosurfactant, shrimp larvae (microcrustacean Artemia salina) were used as an indicator after 24 h of incubation. A solution of the plant extract was used in different concentrations (½ × CMC, 1 × CMC and 2 × CMC). The analyses were conducted in 10 mL penicillin vials containing 10 larvae in 5 mL of synthetic sea salt per vial. The larvae contained in each vial were exposed to 5 mL of the extract solution at concentrations tested for 24 h and then observed for mortality.20 Synthetic sea salt was used as a control. The threshold toxic concentration was defined as the lowest concentration capable of causing the death of the microcrustacean within 24 h. Biosurfactant phytotoxicity test against plant seeds The phytotoxicity of the plant-derived biosurfactant was evaluated in a static test using seed germination and root growth of cabbage (Brassica oleracea), gherkin (Cucumis anguria) and tomato (Solanum licopersicum) according to the study of Tiquia et al.21 A test solution of the extract was prepared in deionized water at different concentrations (½ × CMC, 1 × CMC and 2 × CMC). Toxicity was determined in sterile Petri dishes (10 cm) containing Whatman No. 1 filter paper disks. After five days of incubation in the dark, seed germination, root growth (≥ 5 mm) and the germination index (GI) were calculated according to the relative seed germination and root length formulas. The determination was expressed in the period after 120 h by relative seed germination (GRS), root length (CRR) and seed germination index (GI), as follows:  Characterization of the plant biosurfactant The isolated biosurfactant was also characterized by Fourier transform infrared (FTIR, KBr) spectrometry (Spectrum 400, PerkinElmer). The signals were collected from 400 to 4,000 wave numbers with a resolution of 4 cm-1.22 The isolated biosurfactant was dissolved in dimethylsulfoxide (DMSO) and its respective nuclear magnetic resonance (NMR) spectra were recorded at 25 ºC using a 300 MHz spectrometer (Agilent) operating at 300.13 MHz. The chemical shifts (d) with respect to the tetramethylsilane (TMS) were expressed in ppm. The Libermann-Burchard test was carried out by evaporating 2 mL of the biosurfactant, which was then redissolved with 2 drops of acetic anhydride and 1 drop of concentrated sulfuric acid. Triterpene saponins and steroids produce bluish, green and purplish red coloration, respectively.23 Synthesis of nanoparticles stabilized with plant biosurfactant The isolated biosurfactant was neutralized with a 0.1 M sodium hydroxide solution. Silver nitrate was added to each of these solutions in a 1:3 ratio of silver ions to sodium ions, respectively. The solutions were cooled using an ice bath and stirred continuously using a magnetic stir bar. When the temperature of the mixture reached around 5 ºC, a solution containing sodium borohydride was used to reduce the silver ions, using a ratio of 1:4 moles of sodium borohydride to each mole of silver, respectively. In the end of the reaction, the solution obtained containing silver nanoparticles complexed with biosurfactant (BS-AgNP) was stored at 4 ºC for further experiments.14 Properties and characteristics of silver nanoparticles synthesized and stabilized with plant biosurfactant The absorptive property of the suspension of AgNPs stabilized with isolated biosurfactant was analyzed using UV-Vis spectroscopy (SP-22 digital spectrophotometer, Biospectro), in the wavelength range between 400 and 1000 nm. The stability of the nanoparticles in suspension was determined using the Zeta-Meter 4.0 equipment (Zeta-Meter Inc.). Preliminary analysis of the morphology and size of the synthesized silver nanoparticles was carried out using a scanning electron microscope (JSM-5600, JEOL) at an accelerating voltage of 30 kV. To make the samples conductive, an aliquot of the nanoparticle suspension had to be separated before analysis and deposited on a carbon tape surface coated with a thin layer of gold. Evaluation of antibacterial activity The antimicrobial property of the nanoparticles synthesized with plant biosurfactant was evaluated using the Kirby-Bauer disc diffusion method,24 against Gram-positive (Staphylococcus aureus) and Gram-negative (Escherichia coli) bacterial strains previously isolated at the bioengineering laboratory of the Catholic University of Pernambuco. The antibacterial effect of silver nanoparticles was evaluated using the Kirby-Bauer disk diffusion method.24 A bacterial suspension (100 µL of 5 × 106 CFU mL-1) was spread evenly on the surface of a nutrient agar plate. Next, filter paper discs (about 6 mm in diameter), impregnated with AgNPs stabilized with the plant biosurfactant (100, 200 μg disc-1) were placed on the surface of the agar. The agar plates were then inverted and incubated at 37 ºC for 24 h, posteriorly, the diameter of the inhibition zone around the disk was measured with a ruler.
RESULTS AND DISCUSSION Selection of the extraction process for biosurfactant of plant origin Several techniques can be used to extract plant biosurfactants, from conventional solvent-based methods to emerging techniques such as ultrasound.4,25 In the present study, extraction methods were evaluated with the aim of discovering which one would perform best in obtaining extracts rich in surfactant molecules. The plant-based biosurfactant obtained by adapted heated acid-base extraction18 showed a yield of 2.0 g kg-1 and a reduction in water surface tension from 70 to 50 mN m-1. Using the alcoholic extraction method,17 the biosurfactant showed a yield of 1.5 g kg-1 and a reduction in water surface tension from 70 to 42 mN m-1. The plant extract obtained by the adapted acid-base agitation method18 was able to reduce the surface tension from 70 to 30 mN m-1, with a yield of 1.0 g kg-1. Therefore, the adapted acid-base agitation extraction method18 was selected for further research, since the plant extract presented excellent surfactant properties, demonstrating a superior ability to reduce surface tension compared to the adapted heated acid-base extraction methods18 and alcoholic extraction tested in this study.17 Surfactant properties of plant-based biosurfactants The reduction of surface tension and CMC are essential parameters to evaluate the presence and efficiency of a surfactant.26 The lower concentration of the biosurfactant required to reach the CMC, greater its efficiency.27 The CMC is reached when a further increase in the concentration of the biosurfactant does not result in a further reduction in surface tension. Plant biosurfactants present a CMC in the range of 0.01 g L-1 in their pure state.28,29 However, in crude plant extracts, the CMC values are higher.30 The biosurfactant extracted from tangerine peel using the adapted acid-base agitation methodology18 demonstrated the ability to reduce surface tension, decreasing it from 70 to 30 mN m-1, with a yield of 1.0 g kg-1 and a CMC of 0.7 g L-1. In Figure 2, it can be seen that from the point of 0.7 g L-1, the surface tension remained stable even with the additional increase in concentration.

Until now, CMC values have not been reported in the literature for Citrus reticulata extracts. However, studies carried out by Samal et al.31 and Jarzębski et al.32 reported a CMC of 1 and 0.6 g L-1 for the crude plant extract of Verbascum nigrum L. (mullein) and Sapindus mukorossi, respectively, demonstrating values close to those obtained in the present study. Bezerra et al.33 obtained a CMC of 0.7 g L-1 from Chenopodium quinoa extract, presenting a surface tension of 31.06 mN m-1, for Glycine max, the CMC was 0.8 g L-1, with a surface tension of 32.41 mN m-1, while for Malpighia emarginata the CMC was 0.3 g L-1 with surface tension of 33.09 mN m-1. Plant extracts rich in saponins are capable of reducing the surface tension of water (72 mN m-1) to values between 25 and 35 mN m-1.34 Stability of plant biosurfactant related to surface tension Environmental factors, such as pH and temperature, can influence the activity and stability of a biosurfactant. It is therefore of fundamental importance to study the influence of these parameters when considering the possibility of specific applications for these compounds.35 After carrying out the stability tests, it was possible to observe that the plant biosurfactant showed a slight change in surface tension when subjected to pH variation (2 and 4), reducing the tension to 29 mN m-1, and remained stable in the other variations (6, 8, 10, 12) with a value of 30 mN m-1. While in the temperature variation, the extract showed a stable surface tension in all variations, showing that temperature is not an influential factor in reducing surface tension (Table 1).

Bezerra et al.36 observed that in the extract obtained from C. quinoa, temperature variations did not affect the surface tension, which remained at 31 mN m-1. Regarding pH variation, it was observed that values between 6 and 8 maintained stable surface tension, and the most acidic and alkaline values, 2 and 12, resulted in an increase in tension to 37 mN m-1. Each plant extract has its own particular stability; however, it is known that biosurfactants have good stability when subjected to different temperatures and pH values.27 Emulsification index of plant-based biosurfactant Emulsifiers have been used as flocculating, solubilizing, foaming, emulsifying or demulsifying agents. According to Bezerra et al.,37 for a biosurfactant to be considered a good emulsifier, it is necessary to evaluate the surfactant ability to form stable emulsions of at least 50% for 24 h or more. Table 2 shows the emulsification index for the plant biosurfactant, which showed an emulsification percentage of 50% for all the oils tested, which is an expected result when compared to other plant extracts described in the literature.33,37

Toxicity test with microcrustacean Artemia salina Toxicity can be defined as the ability of a substance to cause a harmful effect on a living organism, which depends on the concentration and properties of the chemical to which the organism is exposed and the time of exposure.38 Artemia salina is a marine organism commonly used in ecotoxicology due to the feasibility of maintaining it on a laboratory scale, its short life cycle, simple conditions for its growth and because it has a low tolerance to environmental changes and high specificity to external influences, which guarantees clear results in the face of small variations in the quality of the environment.39,40 Tests carried out with Artemia salina showed a survival rate of 100%, demonstrating that the biosurfactant extracted from tangerine peel did not present toxicity for all concentrations tested. Similar results were reported by Lira et al.41 and Bezerra et al.36 for microbial biosurfactants. Phytotoxicity test with seeds Phytotoxicity negatively impacts plant growth or fitness and may be associated with cell dysfunction.38 The results of the phytotoxicity test with the plant extract on three plant species are shown in Table 3.

The literature42 considers that a GI of 80% is an indicator of the absence of phytotoxicity. The results obtained in this work show that the biosurfactant of plant origin in the dilutions tested (1 × CMC, ½ × CMC and 2 × CMC) did not have any inhibitory effect on germination for gherkin, tomato and cabbage seeds, with a GI level of over 80% for the plant biosurfactant, respectively, in the concentrations proposed, carried out in triplicate. Araújo et al.43 and Ray et al.44 also did not identify a reduction in root growth in their tests with microbial biosurfactants. Fourier transform infrared spectroscopy (FTIR) The FTIR spectra of the isolated plant-derived surfactant showed absorption peaks characteristic of saponins (Figure 3). The long peak at 3425 cm-1 indicates the presence of hydroxyl groups (-OH). The broad peak at 1589 cm-1 may indicate the presence of carbonyl (C=O) as well as the presence of double bonds (C=C). The peaks at 1589 and 1270 cm-1 indicate the C=C and C-O-C bonds, respectively, with -OH, C-H and C=C being characteristic of saponins, while the C-O-C of glycosidic bonds is characteristic of sapogenins.
The FTIR spectra correspond to signals indicative of saponins in the extract and are in line with the results of studies found in the literature.33,45,46 Bezerra et al.47 obtained similar results with vegetable biosurfactants extracted from the seeds of Chenopodium quinoa and Glycine max and dried fruits of Malpighia emarginata, as when compared to the standard saponin spectrum, it was possible to observe corresponding peaks, in accordance with the results of similar studies found in literature. Nuclear magnetic resonance (NMR) spectroscopy The 1H spectrum of the biosurfactant isolated from the extract (Figure 4) suggested the presence of hydrogens attached to the aliphatic carbon chain in the region between (0-1.5 ppm). This signal is less prominent when compared to the signal present in the carbon chain of a fatty acid, which may suggest that the hydrophobic fractions present in the molecules of the plant extract are in smaller quantities. The signals present between (1.5-2.5 ppm) suggest the presence of hydrogens attached close to the carbons neighboring those with a double bond in their structure or even the carbonyl function. The peaks present between (3-5 ppm) indicate the presence of hydroxyls responsible for the polar fractions of the molecular structures.
The set of signals between 6-8 ppm strongly suggests the presence of hydrogens attached to carbons containing double bonds or even belonging to the phenyl group, very common in polyphenol molecules, which are abundant in orange peels. It is also possible to observe a peak between 9-10 ppm, indicating the presence of the carboxylic acid function and a small signal near 12 ppm, suggesting the presence of the aldehyde function. The spectrum of 13C (Figure 5) showed signals in the region between 0-45 ppm that make up the fractions of carbon-carbon bonds. The peaks found between 50-80 ppm are responsible for possible carbons linked to oxygen, derived from ether or alcohol functions. The signals found between 100-150 ppm certainly come from carbons with double bonds, which may be present in aromatic chains, as suggested by the 1H spectrum, or even in the unsaturated chain. The peaks found between 160-180 ppm suggest the presence of molecules containing the carboxylic acid function as well as the presence of esters. The signal near 200 ppm suggests the presence of an aldehyde or ketone function.
Liebermann-Burchard test In the Liebermann-Burchard test, the tangerine biosurfactant fraction showed a purplish red color, which is indicative of triterpene saponins according to the study of Tsai et al.21 This result corroborates the results obtained by Bezerra et al.33 in which the C. quinoa and G. max fractions also showed the same color. Characterization of silver nanoparticles According to the study of Tyagi et al.48 silver nanoparticles can be revealed by the color change of the solution. Pacheco et al.49 pointed out that one of the main characteristics of localized surface plasmon resonance (LSPR) in nanoparticles is the oscillation of excited electrons, which is limited by the volume of these particles, making it possible to evaluate the presence, uniformity and size of AgNPs through of UV-Vis. When light hits the silver nanoparticles, the electrons on their surface begin to oscillate and resonate with the frequency of the incident light, causing some colors of visible light to be absorbed, thus causing the color of the solution to change as a result of the irradiation of the light captured in LSPR.50 Thus, the synthesis of nanoparticles using the plant extract obtained from tangerine peel as a stabilizer was shown in Figures 6a and 6b by the change in color. This can be confirmed by analyzing the results of UV-Vis spectroscopy (Figure 7), through a well-defined maximum UV-Vis absorption peak characteristic of silver nanoparticles, which is between 400 and 450 nm, corresponding to LSPR.48 It may also indicate that AgNPs have a spherical shape, since particles of this shape have an LSPR absorption light band normally close to 400 nm.48


Scanning electron microscopy at a magnification of 15.000× showed several points with randomly distributed nanoparticles with a spherical morphology (Figure 8). When magnified to 20.000×, particles of varying sizes were identified, but the SEM had a limitation that only allowed the measurement of particles larger than 300 nm, thus excluding the measurement of several particles that had much smaller sizes. The nanoparticles had diameters of 384-568 nm, highlighted by arrows in Figure 7. Comparing the results with the literature,51,52 AgNPs synthesized with microbial biosurfactants showed high-density, rounded structures with diameters in the range of 30-160 nm.

As the distribution was random, it was possible to observe points with agglomerations of AgNPs, and it can be said that the particles exhibited a high surface area, as they were not completely separated from the others.53 The rounded shape presented testifies to the fact that silver nanoparticles have a localized surface plasmon resonance (SPR) absorption light band close to 400 nm.50 The stability of the AgNPs was analyzed using the zeta potential. Previous studies51,53,54 carried out with green synthesized silver nanoparticles have reported values of -23.4, -38.7 and -22.2 mV for microbial biosurfactants. In this work, this parameter reached values of -86.30 ± 4.8 mV for the nanoparticles synthesized with the plant biosurfactant. This value is very far from zero, which shows a strong electrostatic repulsion between the particles, resulting in high stability and a low probability of aggregation or precipitation. Antimicrobial test Pathogenic microorganisms are a major concern today, and the improper use of drugs has led to resistance to conventional antimicrobial agents, becoming a threat to health worldwide.10,55 The development of studies in this area is growing every day in order to find more effective solutions to this problem. In view of this, the antimicrobial potential of silver nanoparticles against strains known to be pathogenic was evaluated in this work. The samples containing the AgNPs synthesized with the biosurfactant showed an inhibition for Escherichia coli (12%), Staphylococcus aureus (16%) and biosurfactant 5% (control) for both microorganisms (Figure 9).
Hassan Afandy et al.56 reported studies attesting to the antibacterial activity of AgNPs synthesized with plant extracts, which presented different results for Gram-positive and Gram-negative bacteria, showing that this factor did not have much influence on the antibacterial activity of the nanoparticles. It can be suggested that the nanoparticle synthesized and stabilized with the biosurfactant probably has a majority of smaller particles, covering a larger surface area and being more effective as an antimicrobial agent.57,58 Rani et al.59 observed that the AgNPs prepared using the filtrate of Aspergillus terreus Thom., 1918 inhibited the growth of both E. coli and S. aureus at concentrations of 11.43 and 32.2 μg mL-1, respectively. However, more in-depth studies are necessary to evaluate the relationship between the ability of nanomaterials to cover different metallic concentrations, as well as the size and uniformity of the particles, since the higher the concentration of stable AgNPs, the greater the activity of AgNPS.60
CONCLUSIONS The acid-base agitation extraction process used in this study proved to be efficient in obtaining a biosurfactant from Citrus reticulata peels. The structural characterization of the biosurfactant suggests that it is a saponin biosurfactant, without toxicity. The extract presented emulsifying and surfactant properties, being effective as a stabilizing agent for silver nanoparticles (BS-AgNPs). The BS-AgNPs obtained were stable, small, and spherical, making them suitable for various biotechnological applications. In addition, the nanoparticles demonstrated antimicrobial activity against pathogens that affect human health. The use of the plant extract as a stabilizer for silver nanoparticles still presents challenges, such as the chemical variability of the extracts and difficulties in standardization for size control. However, this approach is sustainable, aligned with green chemistry, and offers promising prospects with advances in chemical characterization and understanding of interactions between bioactive compounds in extracts and metal surfaces, which may lead to the production of more stable nanoparticles with optimized properties for biomedical, environmental and industrial applications.
ACKNOWLEDGMENTS The authors would like to thank Conselho Nacional de Desenvolvimento Científico (CNPq), Fundação de Amparo á Ciência e Tecnologia do Estado de Pernambuco (FACEPE), Universidade Católica de Pernambuco and Instituto Avançado de Tecnologia e Inovação (IATI), Brazil.
REFERENCES 1. Instituto Brasileiro de Geografia e Estatística (IBGE); https://www.ibge.gov.br/estatisticas/economicas/agricultura-e-pecuaria.html, accessed in March 2025. 2. Panwar, D.; Panesar, P. S.; Chopra, H. K.; Food Rev. Int. 2019, 37, 91. [Crossref] 3. Panwar, D.; Saini, A.; Panesar, P. S.; Chopra, H. K.; Trends Food Sci. Technol. 2021, 111, 549. [Crossref] 4. Kaur, R.; Mishra, V.; Gupta, S.; Sharma, S.; Vaishnav, A.; Singh, S. V. J.; Plant Growth Regul. 2024, 43, 3012. [Crossref] 5. Badve, M.; Humbare, T.; Proceedings of the Indian National Science Academy 2023, 89, 181. [Crossref] 6. Jimoh, A. A.; Lin, J.; Ecotoxicology 2019, 184, 109607. [Crossref] 7. Bezza, F. A.; Tichapondwa, S. M.; Chirwa, E. M. N.; J. Hazard. Mater. 2020, 393, 122319. [Crossref] 8. Farias, C. B. B.; Almeida, F. C. G.; Silva, I. A.; Souza, T. C.; Meira, H. M.; Silva, R. C. F. S. S.; Luna, J. M.; Santos, V. A.; Converti, A.; Banat, I. M.; Sarubbo, L. A.; Electron. J. Biotechnol. 2021, 51, 28. [Crossref] 9. Liu, K.; Sun, Y.; Cao, M.; Wang, J.; Lu, J. R.; Xu, H.; Curr. Opin. Colloid Interface Sci. 2020, 45, 57. [Crossref] 10. Kumar, S. V.; Bafana, A. P.; Pawar, P.; Rahman, A.; Dahoumane, S. A.; Jeffryes, C. S.; Sci. Rep. 2018, 8, 5106. [Crossref] 11. Lee, S. H.; Jun, B. H.; Int. J. Mol. Sci. 2019, 20, 865. [Crossref] 12. Zong, T. X.; Silveira, A. P.; Morais, J. A. V.; Sampaio, M. C.; Muehlmann, L. A.; Zang, J.; Jiang, C. S.; Liu, S. K.; Nanomaterials 2022, 12, 1855. [Crossref] 13. Sultana, A.; Zare, M.; Thomas, V.; Kumar, T. S.; Ramakrishna, S.; Med. Drug Discovery 2022, 15, 100134. [Crossref] 14. Le, A. T.; Tam, P. D.; Huy, P. T.; Huy, T. Q.; Van Hieu, N.; Kudrinskiy, A. A.; Krutyakov, Y. A.; Mater. Sci. Eng. 2010, 30, 910. [Crossref] 15. Ying, S.; Guan, Z.; Ofoegbu, P. C.; Clubb, P.; Rico, C.; He, F.; Hong, J.; Environ. Technol. Innovation 2022, 26, 102336. [Crossref] 16. Abdelghany, T. M.; Al-Rajhi, A. M.; Al Abboud, M. A.; Alawlaqi, M. M.; Ganash Magdah, A.; Helmy, E. A.; Mabrouk, A. S.; BioNanoScience 2018, 8, 5. [Crossref] 17. Dumitrescu, A. M.; Sirbu, R.; Lepădatu, A. C.; Eur. J. Nat. Sci. Med. 2021, 4, 39. [Link] accessed in March 2025 18. Jones, W. P.; Kinghorn, A. D. In Natural Products Isolation; Sarker, S. D.; Latif, Z.; Gray, A. I., eds.; Humana Press: New Jersey, 2006, p. 341. [Crossref] 19. Cooper, D. G.; Goldenberg, B. G.; Appl. Microbiol. 1987, 53, 224. [Crossref] 20. Okumu, M. O.; Mbaria, J. M.; Gikunju, J. K.; Mbuthia, P. G.; Madadi, V. O.; Ochola, F. O.; Jepkorir, M. S.; Toxicon: X 2021, 12, 100082. [Crossref] 21. Tiquia, S. M.; Tam, N. F. Y.; Hodgkis, S. I. J.; Environ. Pollut. 1996, 93, 249. [Crossref] 22. Santos, E. M. S.; Lira, I. R. A. S.; Meira, H. M.; Aguiar, J. S.; Rufino, R. D.; Almeida, D. G.; Casazza, A. A.; Converti, A.; Luna, J. M.; Energies 2021, 14, 467. [Crossref] 23. Tsai, C. E.; Lin, L. H.; Chem. Pap. 2019, 73, 501. [Crossref] 24. Habiba, K.; Bracho-Rincon, D. P.; Gonzalez-Feliciano, J. A.; Villalobos-Santos, J. C.; Makarov, V. I.; Ortiz, D.; Avalos, J. A.; Gonzales, C. I.; Weiner, B. R; Morell, G.; Applied Materials Today 2015, 1, 80. [Crossref] 25. Souza, A. R. C.; Guedes, A. R.; Rodriguez, J. M. F.; Bombardelli, M. C.; Corazza, M. L.; J. Supercrit. Fluids 2018, 140, 137. [Crossref] 26. Silva, R. D. C. F.; Almeida, D. G.; Rufino, R. D.; Luna, J. M.; Santos, V. A.; Sarubbo, L. A.; Int. J. Mol. Sci. 2014, 15, 12523. [Crossref] 27. Dabaghi, S.; Ataei, S. A.; Taheri, A.; BMC Biotechnol. 2023, 23, 2. [Crossref] 28. Xu, M.; Wan, Z.; Yang, X.; Molecules 2021, 26, 6075. [Crossref] 29. Jiang, S. L.; Guan, Y. D.; Chen, X. S.; Ge, P.; Wang, X. L.; Lao, Y. Z.; Xiao, S. S.; Zhang, Y.; Yang, J. M.; Xu, X. J.; Cheng, Y.; Acta Pharmacol. Sin. 2019, 40, 919. [Crossref] 30. Zhang, Q.; Huang, L. L.; Wei, W. C.; Yang, K. K.; Yu, X. Z.; IOP Conf. Ser.: Mater. Sci. Eng. 2019, 479, 012014. [Crossref] 31. Samal, K. C.; Das, C.; Kaustubha, M.; J. Environ. Manage. 2017, 203, 8. [Crossref] 32. Jarzębski, M.; Smułek, W.; Kościński, M.; Białopiotrowicz, T.; Kaczorek, E.; Food Hydrocolloids 2018, 81, 341. [Crossref] 33. Bezerra, K. G.; Silva, I. G.; Almeida, F. C.; Rufino, R. D.; Sarubbo, L. A.; Biocatal. Agric. Biotechnol. 2021, 34, 102036. [Crossref] 34. Silva, N. M. P. R.; Meira, H. M.; Almeida, F. C. G.; da Silva, R. C. F. S.; Almeida, D. G.; Luna, J. M.; Santos, V. A.; Sarubbo, L. A; Sep. Purif. Rev. 2019, 48, 267. [Crossref] 35. Cavalcanti, M. H.; Magalhães, V. M.; Silva, N. M. R.; Farias, C. B.; Almeida, F. C.; Sarubbo, L. A.; Chemical Engineering Transactions 2020, 79, 55. [Crossref] 36. Bezerra, K. G.; da Costa, K. I.; dos Santos, J. C.; da Silva, E. S.; Luna, J. M.; de Almeida, F. C.; Rufino, R. D.; Sarubbo, L. A.; Chemical Engineering Transactions 2023, 99, 217. [Crossref] 37. Bezerra, K. G.; Durval, I. J.; Silva, I. A.; Almeida, F. C. G.; Melo, Y. T. F.; Runifno, R. D.; Sarubbo, L. A.; Chemical Engineering Transactions 2020, 79, 211. [Crossref] 38. Santos, D. K. F.; Meira, H. M.; Rufino, R. D.; Luna, J. M.; Sarubbo, L. A.; Process Biochem. 2017, 54, 20. [Crossref] 39. Pinto, M. I. S.; Guerra, J. M. C.; Meira, H. M.; Sarubbo, L. A.; Luna, J. M.; Foods 2022, 11, 561. [Crossref] 40. Lima, M. F. F.; Silva, J. W. S. A.; Silva, J. K.; Moura, A. H. N.; Lopes, R. L. F.; Cordeiro B. A.; de Melo, A. F. M.; Brazilian Journal of Health Review 2019, 2, 5950. [Crossref] 41. Lira, I. R. A. S.; Santos, E. M. D. S.; Selva Filho, A. A.; Farias, C. B. B.; Guerra, J. M. C.; Sarubbo, L. A.; Luna, J. M.; Chemical Engineering Transactions 2020, 79, 457. [Crossref] 42. Patel, K.; Patel, M.; Bioresour. Technol. 2020, 315, 123861. [Crossref] 43. Araújo, H. W.; Andrade, R. F.; Montero-Rodríguez, D.; Rubio-Ribeaux, D.; Silva, C. A. A.; Campos-Takaki, G. M.; Microb. Cell Fact. 2019, 18, 2. [Crossref] 44. Ray, M.; Kumar, V.; Banerjee, C.; J. Environ. Chem. Eng. 2022, 10, 107190. [Crossref] 45. El-Keiy, M. M.; Radwan, A. M.; Mohamed, T. M.; J. Biosci. Med. 2019, 7, 70. [Crossref] 46. Norouzpour, M.; Nabipour, M.; Azdarpour, A.; Akhondzadeh, H.; Santos, R. M.; Keshavarz, A.; Fuel 2022, 318, 123652. [Crossref] 47. Bezerra, K. G.; Meira, H. M.; Veras, B. O.; Stamford, T. C.; Fernandes, E. L.; Converti, A.; Rufino, R. D.; Sarubbo, L. A.; Processes 2023, 11, 879. [Crossref] 48. Tyagi, P. K.; Mishra, R.; Khan, F.; Gupta, D.; Gola, D.; Biointerface Res. Appl. Chem. 2020, 10, 6587. [Crossref] 49. Pacheco, P. G. F.; Ferreira, D. L.; Pereira, R. S.; Vivas, M. G.; Analyst 2023, 148, 5262. [Crossref] 50. Pryshchepa, O.; Pomastowski, P.; Buszewski, B.; Adv. Colloid Interface Sci. 2020, 284, 102246. [Crossref] 51. Durval, I. J. B.; Meira, H. M.; de Veras, B. O.; Rufino, R. D.; Converti, A.; Sarubbo, L. A.; Fermentation 2021, 7, 233. [Crossref] 52. Elakkiya, V. T.; SureshKumar, P.; Alharbi, N. S.; Kadaikunnan, S.; Khaled, J. M.; Govindarajan, M.; Saudi J. Biol. Sci. 2020, 27, 1892. [Crossref] 53. Nehal, N.; Singh, P.; Mater. Today:Proc. 2022, 50, 2555. [Crossref] 54. Radha, P.; Suhazsini, P.; Prabhu, K.; Jayakumar, A.; Kandasamy, R.; J. Surfactants Deterg. 2020, 23, 119. [Crossref] 55. Salam, M. A.; Al-Amin, M. Y.; Salam, M. T.; Pawar, J. S.; Akhter, N.; Rabaan, A. A.; Alqumber, M.; Healthcare 2023, 11, 1946. [Crossref] 56. Afandy, H. H.; Sabir, D. K.; Aziz, S. B.; Nanomaterials 2023, 13, 1327. [Crossref] 57. Ethiraj, A. S.; Jayanthi, S.; Ramalingam, C.; Banerjee, C.; Mater. Lett. 2016, 185, 526. [Crossref] 58. Yuan, Y. G.; Peng, Q. L.; Gurunathan, S.; Int. J. Mol. Sci. 2017, 18, 569. [Crossref] 59. Rani, R.; Sharma, D.; Chaturvedi, M.; Yadav, J. P.; J. Nanomed. Nanotechnol. 2017, 8, 457. [Crossref] 60. Vishwanath, R.; Negi, B.; Green Sustainable Chem. 2021, 4, 100205. [Crossref]
Associate Editor handled this article: Marcela M. Oliveira |
On-line version ISSN 1678-7064 Printed version ISSN 0100-4042
Qu�mica Nova
Publica��es da Sociedade Brasileira de Qu�mica
Caixa Postal: 26037
05513-970 S�o Paulo - SP
Tel/Fax: +55.11.3032.2299/+55.11.3814.3602
Free access










